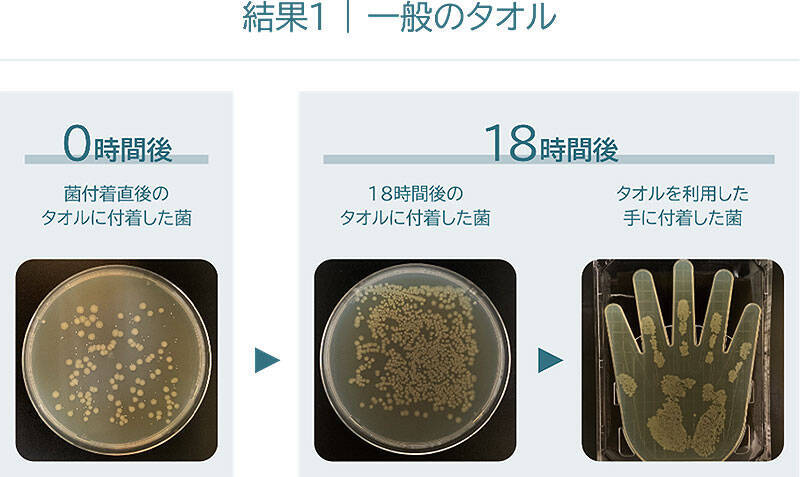
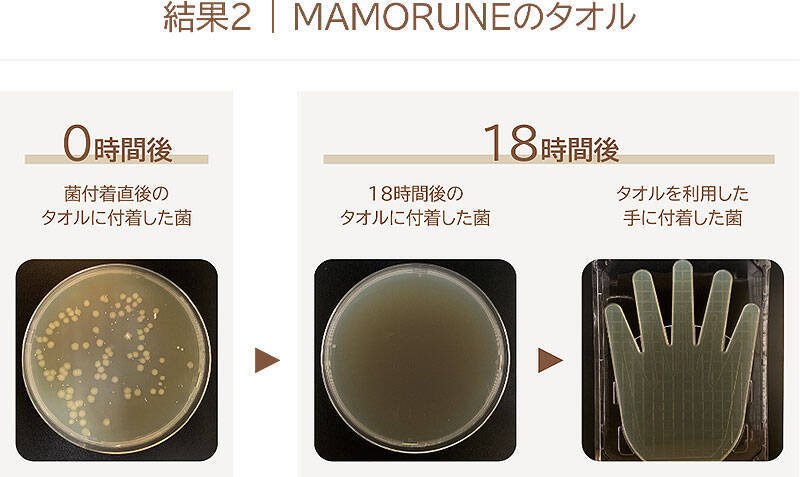

「こんなタオル、待ってた!」
“本当の清潔” を考えた、生乾き臭が発生しない抗菌タオル「MAMORUNE」(マモルネ)が、満を持して誕生―――。
200回以上洗っても抗菌機能が長続き

愛知県名古屋市に本社をおき、半世紀にわたり、綿花の輸入から紡績、染色整理加工まで一貫して生産する紡績メーカー KBツヅキ は、柔らかさや吸水性に加え、200回以上洗っても抗菌機能が長続きするタオル「MAMORUNE」の開発に成功。
9月15日から、公式サイト TSUZUKI COTTON LABO(https://tsuzuki-cotton.com/)でフルラインアップ販売される
一度でも手や顔を拭くと、知らない間に菌が増殖していく一般的なタオルと違い、この KBツヅキ 最新タオル「MAMORUNE」は、MAMORUNE の抗菌機能は長持ちし、愛用する間ずっと清潔。
そんな MAMORUNE のこだわりについて、ここで詳しくチェックしていこう↓↓↓
200回以上洗濯しても抗菌効果が持続 生乾き臭が発生しない

タオルに機能を定着させるときに使われるのが「バインダー」(固着剤)。
MAMORUNE は、少量のバインダーでもしっかり機能を定着させる技術により、タオル本来の柔らかさを保ったまま機能を持続させることに成功。
KBツヅキ独自技術のバインダー技術は、特許を取得。抗菌効果は検査機関でも実証済みで、高いレベルの細菌の増殖抑制効果が確認されている。これにより、200回以上洗っても生乾き臭の発生を防ぐことができる。
200回以上洗濯しても柔らかさと吸水性をキープ

紡績工場に届く綿花は、運搬の過程で圧縮されて到着し、その後の紡績~製織の工程でさらにダメージが蓄積される。
一般的にはそのまま糸に加工されるなか、KBツヅキ では、20~40日かけじっくり綿花に水分を含ませ、乾き傷んだ綿花を元の瑞々しい状態に戻していく。
また、MAMORUNEには、KBツヅキ独自紡績方法「MFTS方式」を採用し、毛羽落ちしにくく耐久性がありながらも、ふんわりとした風合いが持続するタオルを生産することに成功した。
350もの有害物質残留試験をクリア
日常的に接する繊維製品は、一本の糸から製品として店頭に陳列されるまで、さまざまな素材が異なる場所で処理され作り上げられている。
これらの製造過程の多くにおいて、身体に有害な成分が混入するリスクもある。
MAMORUNE は、KBツヅキ独自試験により、ホルムアルデヒドや残留農薬など、350 もの有害物質の在留試験をクリアしている。
SDGsに配慮したタオル

アパレル産業・繊維産業は、環境負荷の大きな産業といわれているなか、KBツヅキでは、その責任に正面から向き合い、持続可能な社会づくりに貢献するべく、企業活動全てにおいて環境に配慮した取り組みを推進中。
サステナブルな環境で製造された MAMORUNE を使用することで、エシカル消費にもつなげていく。
トレーサビリティの取り組み
KBツヅキでは、綿花の輸入から紡績、染色に至るまでの一連の工程を一貫して行うことで、トレーサビリティに対応できる体制を確保。
輸入する綿花も「原産国証明」が発行されているものだけに限定し、さらに人権や労働環境が適切に守られている綿だけを使用している。
ゼロエミッションをめざして

工場から出る廃棄物ゼロをめざし、紡績時に発生する落ち綿(短い綿くず)を使用し、「リサイクル糸」を生産。このリサイクル糸は、軍手を生産する際の縫い糸として販売している。
CO2の削減
紡績において広く採り入れられている「粗紡」という工程を省くことで、使用電力量とCO2排出量を削減。
CO2の削減量は、年間約3,200トンで、これは東京ドーム1.3つ分に(ひと月で太番手3,000梱・中番手1,000梱生産した場合)。
タオルのリサイクル技術への挑戦
KBツヅキは、使用後のタオルなどの綿製品を回収し、機械にかけて繊維の状態に戻し、再び糸を作る「反毛」の技術開発に挑戦中。反毛で作られた糸を原料とし、再び製品化につなげていく。
排水による環境汚染にも配慮
KBツヅキでは、染色工程の精練漂白に苛性ソーダや塩素系漂白剤を使用しないため、PH調整などに用いる水や薬品の量も抑え、従来法との比較で水の使用量を約40%、排水汚濁物質を約50%低減した。
防災の備えやキャンプ用品としても

―――毎日使うタオルを通して、毎日の健やかな暮らしを守りたいという想いから開発された抗菌タオル、MAMORUNE。
抗菌効果が長続きするのが特徴で、菌の増殖を防ぎ清潔を保つことができ、防災用として備えたり、キャンプ用品としての使用するのもおすすめ。
好みの使い心地に合わせ、「MAMORUNE STANDARD」「MAMORUNE PURE TOUCH」「MAMORUNE POINT TOUCH」の3種類から選べるから、気になる人は、公式サイトをチェックしてみて↓↓↓
https://tsuzuki-cotton.com/






































![BE-PAL(ビ-パル) 2024年 10 月号【特別付録: AIGLE 2WAY"はっ水"MINIボストン】[雑誌]](https://m.media-amazon.com/images/I/51noLuhXazL._SL500_.jpg)


![[キャプテンスタッグ] キャリーバッグ 600D 2~3泊対応 マチ幅拡張機能付 2wayリュックスタイル(33~48L) BK](https://m.media-amazon.com/images/I/41FD0WhjNzL._SL500_.jpg)
![[VELSKYF] 現役客室乗務員監修 スーツケース キャリーケース キャリーバッグ 機内持ち込み TSAダイヤルロック[日本企業企画]一部パーツ無期限メーカー保証 ダブルキャスター (Sサイズ 1-3泊 2.8kg 37L ワインレッド 深紅)](https://m.media-amazon.com/images/I/31kz4Sfb2eL._SL500_.jpg)
![[AM Aomoide] スーツケース 機内持ち込み フロントオープン TSAローク搭載 ファスナー式 キャリーケース Sサイズ USBポート付き カップホルダー付き 静音 360度回転キャスター 超軽量 ビジネス 出張 1-3泊 41リットル (ダークブラック, Sサイズ/機内持込(1-3泊))](https://m.media-amazon.com/images/I/41Blf7Y8brL._SL500_.jpg)


